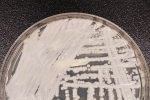

Notícias

Quem tem a doença também terá direito ao uso de vagas preferenciais em estacionamentos coletivos

Proprietários interessados podem se inscrever gratuitamente para o serviço

Centro de Controle de Zoonoses disponibiliza vacinação antirrábica para animais abrigados e comunidade local.

O Dia D aconteceu neste último sábado (15)

Além do curso sobre Método Pilates e outras cinco opções estão com as matrículas abertas

O atendimento será realizado entre 8h e 13h

O ubatubense integra a comunidade quilombola do município e foi eleito delegado durante as pré-conferências de saúde, no seguimento de usuário do SUS

Ação busca a conscientização sobre hepatites virais

Até hoje, cidade vacinou apenas 43,95% do público alvo com o imunizante contra gripe

Atualmente, o CCV conta com cerca de 4 mil voluntários em todo o Brasil

Sobrepeso da fase adulta pode ser evitado, desde que sejam tomadas algumas medidas preventivas durante a infância e adolescência

Ação conta com apoio da Prefeitura de Pindamonhangaba, por meio das secretarias de Saúde, Assistência Social, e de Mulher, Família e Direitos Humanos

Proposta busca amenizar a saudade dos familiares

Poucas semanas após a finalização das sessões, os fios voltam a nascer, mas aspecto igual ao pré-tratamento pode levar 12 meses para retornar

Os exames foram contratados por meio de Ata de Registro de Preços - Pregão Eletrônico E26/2023

Lema este ano é Doe sangue, doe plasma, compartilhe a vida

Soro antiescorpiônico age neutralizando o veneno de escorpião na circulação sanguínea
Paciente está internado em Campinas

Dia Nacional de Luta contra Queimaduras é lembrado nesta terça

Prefeitura inicia imunização de funcionários e frequentadores com aplicação de vacinas até o final de junho

Estudos apontam...

O anúncio ocorreu na última sexta-feira (02)

Cobertura vacinal no estado de São Paulo está em 32,9%, com mais de 6,1 milhões de doses aplicadas

Por meio do Programa Saúde com Agente, o objetivo é aprimorar os serviços oferecidos à população.

Os atendimentos foram realizados tanto de forma presencial quanto por meio de teleconsultas



